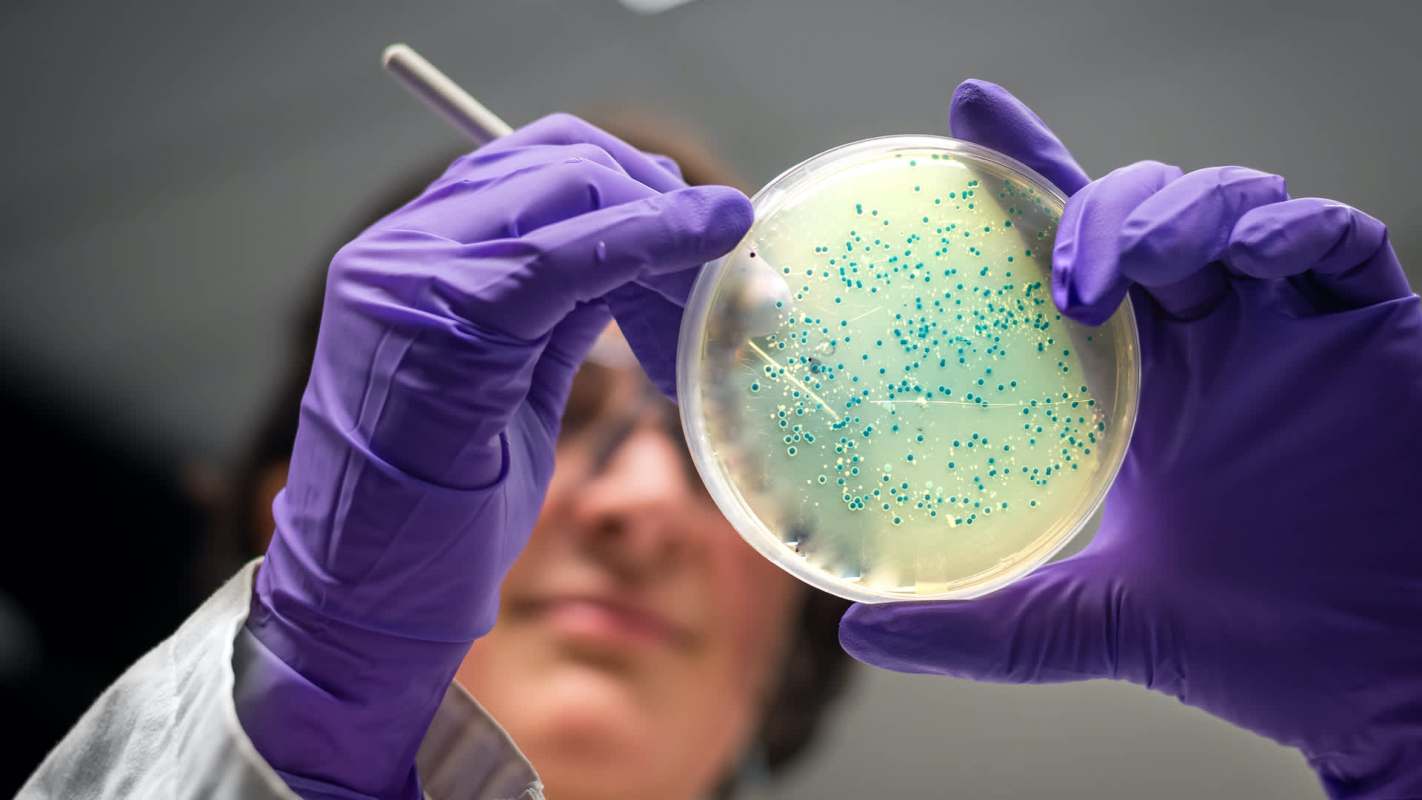
Scientists have found that a corkscrew-shaped bacterium that causes Lyme disease has a hidden vulnerability.

Scientists from Northwestern University and Uniformed Services University have found that the corkscrew-shaped bacterium Borrelia burgdorferi, which causes Lyme disease, has a hidden vulnerability that could make it easier to disable.
According to a summary of the findings published by News Medical Life Sciences, the team explained that if Lyme disease is left untreated, it can cause lingering symptoms such as fatigue, fever, and inflammation. But manganese, a mineral that is beneficial for humans' metabolic health as well as bone and wound healing, could be the silver bullet.
While the mineral normally buffers the bacteria against their host's immune system, "if B. burgdorferi is either starved of or overloaded with manganese, the bacteria become highly vulnerable to the host's immune system or treatments they would otherwise resist," according to News Medical.
The scientists noted that targeting the bacteria with manganese could lead to new and improved treatments for Lyme disease, incidences of which have been increasing worldwide because of rising temperatures. For instance, the Czech Republic and United States have experienced record numbers of cases, and officials believe a longer fall is the main culprit. Since ticks can survive even in winter, they have more time to breed and more opportunities to expand their territories.
While there are no vaccines to treat Lyme disease, the researchers believe their discovery could be a game-changer, helping prevent many cases. According to News Medical, which cited the Centers for Disease Control and Prevention, nearly 500,000 Americans are diagnosed with Lyme disease each year.
With the changing climate making it easier to contract the disease, it's more important than ever to find an alternative to antibiotics, which are the only treatment but kill gut bacteria. It appears mighty manganese might be the perfect solution.
Get cost-effective air conditioning in less than an hour without expensive electrical work The Merino Mono is a heating and cooling system designed for the rooms traditional HVAC can't reach. The streamlined design eliminates clunky outdoor units, installs in under an hour, and plugs into a standard 120V outlet — no expensive electrical upgrades required. And while a traditional “mini-split” system can get pricey fast, the Merino Mono comes with a flat-rate price — with hardware and professional installation included. |
"By disrupting the delicate balance of manganese in B. burgdorferi, it may be possible to weaken the pathogen during infection," USU's Michael Daly said. "Manganese is an Achilles' heel of its defenses."
|
Would you live in a home made of bacteria? Click your choice to see results and speak your mind. |
Get TCD's free newsletters for easy tips to save more, waste less, and make smarter choices — and earn up to $5,000 toward clean upgrades in TCD's exclusive Rewards Club.